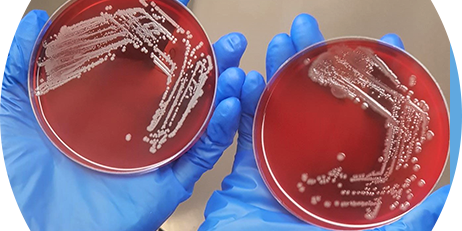

Spectur to provide emergency surf lifesaving beacons
Internet of things security solutions provider Spectur has announced its largest sales contract to date for an emergency response beacon network for Surf Lifesaving New South Wales. The contract will see the company provide emergency response beacons over the next five months to improve safety at a number of beaches in the state. The contract…